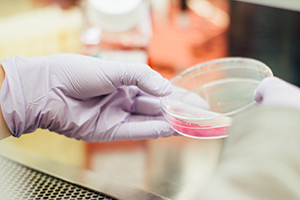

In a recent article published in International Biopharmaceutical Industry, Taconic Biosciences' Dr. Alexander Maue highlights the importance of the mouse gut microbiome and its impact on experimental reproducibility. There is an ongoing reproducibility crisis in the research community, and stabilizing the microbiome of a cohort of mice for multiple generations make take away one contributing factor:
 "Investigators continually seek to improve the reproducibility of their results and the translatability of their preclinical work, while recognising that both goals pose challenges. In a 2016 Nature survery, over 70% of researchers said they were unable to reproduce their own studies. For evidence that translatability from the lab to the clinic remains problematic, one needs to look no further than this fact: nine out of 10 drug candidates fail at the clinical trial stage."
"Investigators continually seek to improve the reproducibility of their results and the translatability of their preclinical work, while recognising that both goals pose challenges. In a 2016 Nature survery, over 70% of researchers said they were unable to reproduce their own studies. For evidence that translatability from the lab to the clinic remains problematic, one needs to look no further than this fact: nine out of 10 drug candidates fail at the clinical trial stage."
Read* the complete International Biopharmaceutical Industry Publication at: issuu.com
"Investigators continually seek to improve the reproducibility of their results and the translatability of their preclinical work, while recognising that both goals pose challenges. In a 2016 Nature survery, over 70% of researchers said they were unable to reproduce their own studies. For evidence that translatability from the lab to the clinic remains problematic, one needs to look no further than this fact: nine out of 10 drug candidates fail at the clinical trial stage."
"Investigators continually seek to improve the reproducibility of their results and the translatability of their preclinical work, while recognising that both goals pose challenges. In a 2016 Nature survery, over 70% of researchers said they were unable to reproduce their own studies. For evidence that translatability from the lab to the clinic remains problematic, one needs to look no further than this fact: nine out of 10 drug candidates fail at the clinical trial stage."
















.jpg)

.jpg)
.jpg)
.jpg)
.jpg)





.jpg)


.jpg)
.jpg)




.jpg)





.jpg)

.jpg)


